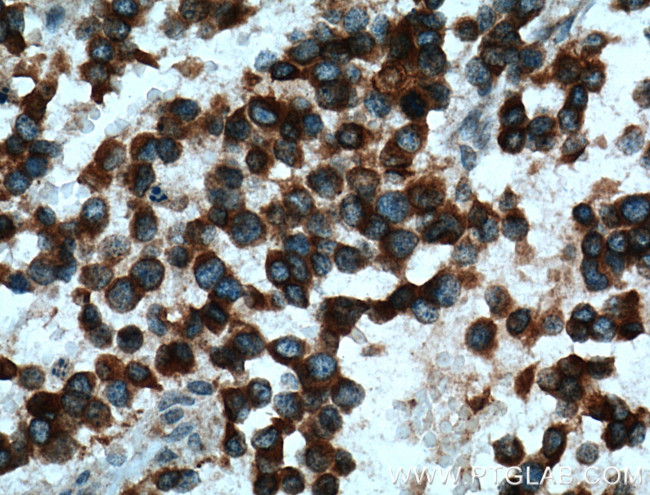
Kir4.1 Antibody in Immunohistochemistry (Paraffin) (IHC (P))

Search
Proteintech
Kir4.1 Polyclonal Antibody
{{$productOrderCtrl.translations['antibody.pdp.commerceCard.promotion.promotions']}}
{{$productOrderCtrl.translations['antibody.pdp.commerceCard.promotion.viewpromo']}}
{{$productOrderCtrl.translations['antibody.pdp.commerceCard.promotion.promocode']}}: {{promo.promoCode}} {{promo.promoTitle}} {{promo.promoDescription}}. {{$productOrderCtrl.translations['antibody.pdp.commerceCard.promotion.learnmore']}}
产品信息
12503-1-AP
种属反应
已发表种属
宿主/亚型
分类
类型
抗原
偶联物
形式
浓度
规格
纯化类型
保存液
内含物
保存条件
运输条件
产品详细信息
Immunogen sequence: ETIRFSQHA VVASHNGKPC LMIRVANMRK SLLIGCQVTG KLLQTHQTKE GENIRLNQVN VTFQVDTASD SPFLILPLTF YHVVDETSPL KDLPLRSGEG DFELVLILSG TVESTSATCQ VRTSYLPEEI LWGYEFTPAI SLSASGKYIA DFSLFDQVVK VASPSGLRDS TVRYGDPEKL KLEESLREQA EKEGSALSVR ISNV (224-426 aa encoded by B C034036)
靶标信息
The KIR (for inwardly rectifying potassium channel) family of potassium channels possess a greater tendency to allow potassium to flow into the cell rather than out of it. KIR4.1, also known as Kir1.2, is highly expressed in brain including glial cells, astrocytes and cortical neurons. KIR4.1 is also expressed in myelin-synthesizing oligodendrocytes and is crucial to myelination in the developing nervous system. The gene encoding human KIR4.1 maps to chromosome 1. KIR4.2, also known as Kir1.3, is expressed in kidney, lung, heart, thymus and thyroid during development. The gene encoding human KIR4.2 maps to chromosome 21 in the Down syndrome chromosome region 1, and KIR4.2 may play a role in the pathogenesis of Downs syndrome. KIR5.1 forms functional channels only by coexpression with either KIR4.1 or KIR4.2 in the kidney and pancreas.
仅用于科研。不用于诊断过程。未经明确授权不得转售。
生物信息学
蛋白别名: ATP-dependent inwardly rectifying potassium channel Kir4.1; ATP-sensitive inward rectifier potassium channel 10; ATP-sensitive inward rectifier potassium channel KAB-2; BIR10; BIRK1; BIRK10; Brain-specific inwardly rectifying K(+) channel 1; glial ATP-dependent inwardly rectifying potassium channel KIR4.1; Inward rectifier K(+) channel Kir1.2; Inward rectifier K(+) channel Kir4.1; inward rectifier K+ channel KIR1.2; KCNJ13 PEN; kir4.1; Potassium channel, inwardly rectifying subfamily J member 10; potassium inwardly-rectifying channel, subfamily J, member 10; potassium voltage-gated channel subfamily J member 10; unnamed protein product
基因别名: BIR10; BIRK-1; BIRK-10; Kab-2; KCNJ10; KCNJ13-PEN; KIR1.2; KIR4.1; SESAME
UniProt ID: (Human) P78508, (Rat) P49655, (Mouse) Q9JM63
Entrez Gene ID: (Human) 3766, (Rat) 29718, (Mouse) 16513